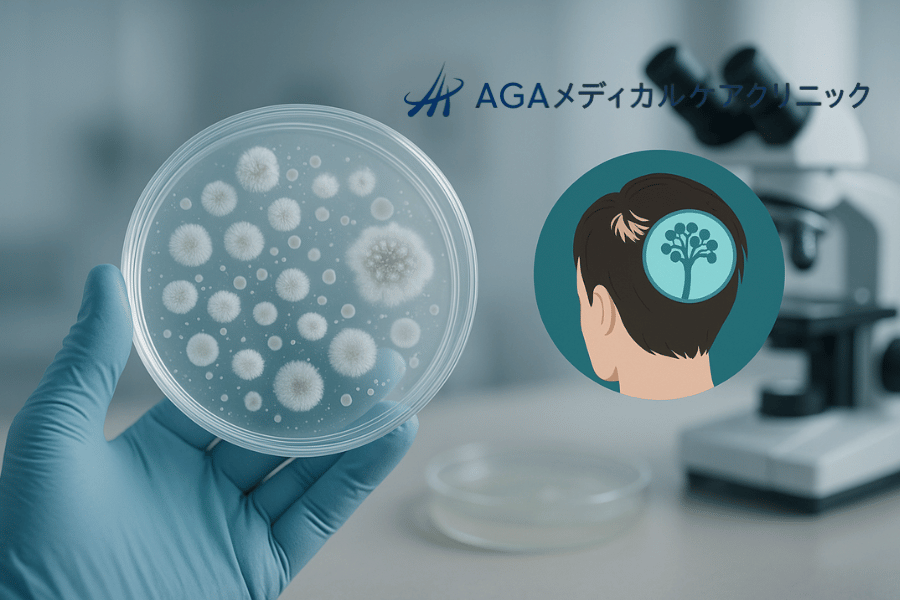
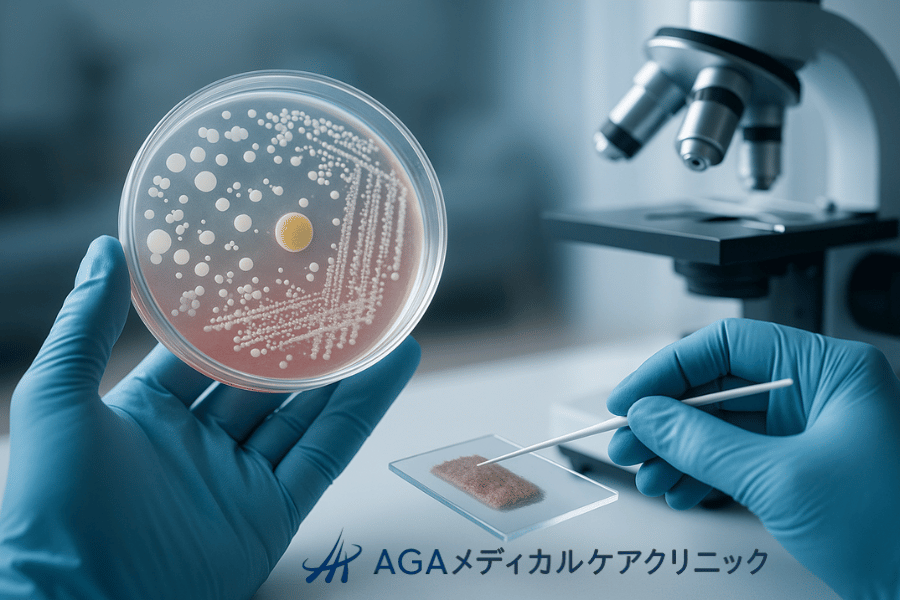

薄毛や抜け毛の悩みは、多くの方が抱える深刻な問題です。しかし、その原因は一人ひとり異なり、自己判断でケアをしても、なかなか改善が見られないことも少なくありません。
本当の原因を突き止めるためには、専門的な視点からの正確な診断が大切です。
この記事では、薄毛の原因を科学的に解明するために医療機関で行われる「頭皮・毛髪の直接検査」について、詳しく解説します。
ダーモスコピー(トリコスコピー)を用いた頭皮の拡大観察から、毛髪の成分分析、さらには組織の一部を調べる生検まで、さまざまな検査法が存在します。
それぞれの検査で何がわかり、どのような場合に有効なのかを理解することで、ご自身の悩みの解決に向けた第一歩を踏み出すことができるでしょう。
トリコスコピー(毛髪鏡検査) – 頭皮と毛髪を拡大して観察
薄毛や頭皮トラブルの原因を探る上で、最初に行うことが多い基本的な検査がトリコスコピーです。特殊な拡大鏡(ダーモスコープ)を用いて、頭皮や毛髪の状態を詳細に観察します。
医師が直接、視覚的に情報を得ることで、診断の精度を高めます。
トリコスコピーとはどのような検査か

トリコスコピーは、ダーモスコピーとも呼ばれる皮膚の顕微鏡検査を頭皮と毛髪に応用したものです。
数十倍から数百倍に拡大して観察するため、肉眼では確認できない毛穴の状態、頭皮の色、血管の形状、毛髪の太さや密度の変化などを詳細に把握できます。
検査に伴う痛みや体への負担は全くなく、その場で結果を確認できるため、患者さんにとっても分かりやすい検査法です。
診察室で簡単に行えるため、多くの皮膚科や薄毛治療専門クリニックで導入しています。
検査で明らかになる頭皮の状態

健康な頭皮は青白い色をしていますが、炎症や血行不良などがあると、その状態が色に現れます。トリコスコピーを用いると、頭皮の色調の変化を正確に捉えることができます。
例えば、赤みがかっている場合は炎症の存在を示唆し、脂漏性皮膚炎や接触皮膚炎などが疑われます。黄色っぽく見える場合は、皮脂の過剰な分泌や酸化が考えられます。
また、毛穴の詰まりやフケ、乾燥の状態も確認でき、頭皮環境の全体的な評価に役立ちます。これらの情報は、適切なスカルプケアや治療法の選択に直結する重要な手がかりとなります。
頭皮の炎症と血管パターン
頭皮の炎症の有無や程度は、血管のパターンを観察することでより詳しく評価できます。例えば、円形脱毛症の活動期には、特徴的な黒点(ブラックドット)や感嘆符毛(かんたんふもう)が見られます。
また、乾癬(かんせん)や脂漏性皮膚炎など、特定の皮膚疾患に固有の血管の形状(点状血管や樹枝状血管など)を観察することで、他の脱毛症との鑑別診断に役立てます。
このように、血管の状態を詳細に分析することは、正確な診断を下す上で非常に重要です。
毛髪の密度や太さの評価
薄毛の進行度を客観的に評価するためには、毛髪の密度(単位面積あたりの本数)と一本一本の太さの計測が重要です。トリコスコピーでは、特定の範囲内の毛髪の本数を数え、密度を算出します。
同時に、マイクロメーターを用いて毛髪の直径を測定し、細くなっている毛(軟毛化)の割合を調べます。
特に男性型および女性型脱毛症(AGA/FAGA)では、毛髪の軟毛化が特徴的な所見です。
太い毛髪の中に細い毛髪が混在している状態を「毛径の多様性」と呼び、これが確認されるとAGA/FAGAの可能性が高まります。定期的にこの変化を観察することで、治療効果の判定にも利用します。
脱毛症の種類の鑑別
トリコスコピーによる詳細な観察は、さまざまな脱毛症を見分ける上で極めて有効です。それぞれの脱毛症には特徴的な所見があり、それらを捉えることで診断を絞り込みます。
例えば、円形脱毛症では前述の黒点や感嘆符毛、断毛などが見られます。一方で、牽引性脱毛症では、特定の方向に引っ張られることで生じる切れ毛や、毛穴の炎症が観察できます。
瘢痕性脱毛症(はんこんせいだつもうしょう)のように、毛包が破壊され再生不能になる重篤な状態では、毛穴の消失といった所見を確認します。
これらの情報を総合的に判断し、適切な治療方針を立てます。
トリコスコピーの主な観察所見
| 観察所見 | 特徴 | 関連する可能性のある疾患 |
|---|---|---|
| 毛径の多様性 | 太い毛と細い毛が混在する | 男性型および女性型脱毛症(AGA/FAGA) |
| 黒点(ブラックドット) | 毛穴に黒い点として見える断毛 | 円形脱毛症(活動期) |
| 感嘆符毛 | 根本が細く、毛先が太い毛髪 | 円形脱毛症(活動期) |
| 毛穴の消失 | 毛を生み出す毛包が破壊されている状態 | 瘢痕性脱毛症 |

毛髪引き抜き試験(プルテスト) – 脱毛の程度を評価

毛髪引き抜き試験は、現在どのくらいの量の毛が抜けやすい状態にあるのか、つまり脱毛の活動性を評価するためのシンプルで古典的な検査です。
医師が指で毛髪を軽く引っ張り、その際に抜ける毛髪の本数や状態を観察します。
毛髪引き抜き試験の基本的な手順
検査は非常に簡単です。医師が親指、人差し指、中指の3本の指で、約50本から60本程度の毛束をつかみ、頭皮から毛先に向かって一定の力でゆっくりと引っ張ります。
この操作を、前頭部、側頭部、頭頂部など、頭皮の複数個所で行います。このとき、強く引っ張りすぎると健康な毛まで抜けてしまうため、熟練した医師による力加減が重要です。
検査前に数日間シャンプーを控えるなどの特別な準備は通常必要ありませんが、正確な評価のために当日の整髪料の使用は控えることが望ましいです。
正常な脱毛と異常な脱毛の見分け方

健康な人でも、ヘアサイクルの過程で1日に50本から100本程度の毛髪は自然に抜けています。毛髪引き抜き試験において、一度に抜ける本数が6本未満であれば、多くの場合、生理的な範囲の脱毛と考えます。
しかし、6本以上、特に10本以上の毛髪が容易に抜ける場合は、何らかの異常な脱毛が起きている可能性が高いと判断します。
この本数はあくまで目安であり、患者さんの毛量や他の所見と合わせて総合的に評価します。
テスト結果が示す脱毛症の活動性
この試験で多くの毛髪が抜ける場合、それは「休止期脱毛」が活発に進行していることを示唆します。
休止期脱毛は、成長期にあるべき毛髪が何らかの原因で一斉に休止期に入り、その後まとめて脱毛する現象です。
代表的なものに、出産後脱毛症、急性疾患やストレスに伴う脱毛、薬剤性の脱毛などがあります。
毛髪引き抜き試験で陽性(多くの毛が抜ける)となった場合、これらの疾患を念頭に置いて、さらに詳しい問診や血液検査などを進めることになります。
逆に、AGAのようにゆっくりと毛が細くなるタイプの脱毛症では、初期にはこの試験で陽性にならないこともあります。
他の検査との組み合わせの重要性
毛髪引き抜き試験は、あくまで脱毛の「活動性」を評価するスクリーニング的な検査です。この検査だけで脱毛症の原因を特定することはできません。
なぜなら、抜けたという事実だけでは、その背景にある疾患まではわからないからです。そのため、
この試験の結果と、先述のトリコスコピーによる頭皮や毛髪の状態、後述するトリコグラムによる毛根の分析、そして血液検査などの結果を総合的に組み合わせることが、正確な診断には大切です。
それぞれの検査が持つ役割を理解し、多角的にアプローチします。

トリコグラム – 抜いた毛髪の顕微鏡検査で成長期・休止期の割合を分析
トリコグラムは、意図的に引き抜いた毛髪を顕微鏡で詳細に観察し、毛根の状態を分析する検査です。
これにより、正常なヘアサイクルが維持されているか、あるいは乱れが生じているかを評価します。
トリコグラムの検査方法と目的
検査では、まず毛髪引き抜き試験と同様に、特定の部位から約50本の毛髪を毛抜き(攝子)などを使って引き抜きます。採取した毛髪の毛根部分を顕微鏡下に置き、その形状や状態を観察することが目的です。
毛髪は「成長期」「退行期」「休止期」というサイクルを繰り返しており、それぞれの時期で毛根の形が異なります。
この検査では、抜去した毛髪がどの時期に当たるのかを一本一本分類し、その割合を算出します。これにより、ヘアサイクル全体のバランスを評価し、脱毛の原因を探る手がかりを得ます。
毛周期(ヘアサイクル)の分析

毛髪一本一本は、独立した周期で成長と脱毛を繰り返しています。この一連の流れが毛周期(ヘアサイクル)です。トリコグラムは、このミクロな周期の状態を可視化する検査と言えます。
成長期毛と休止期毛の割合
健康な頭皮では、全毛髪のうち約85%〜90%が成長期にあり、残りの約10%〜15%が休止期にあるとされています。

トリコグラムでこの割合を調べ、休止期毛の割合が20%を超えている場合、異常な休止期脱毛が起きていると判断します。
例えば、急激なストレスや栄養障害によって成長期の毛が一斉に休止期に移行すると、この割合が顕著に増加します。この数値をみることで、脱毛のタイプや重症度を客観的に評価できます。
毛根の形状からわかること
毛根の形状は、毛周期の段階を反映しています。正常な成長期毛の毛根は、ラグビーボールのように丸みを帯び、毛包にしっかりと包まれています。
一方、休止期毛の毛根は棍棒のような形(棍毛)をしており、メラニン色素も少なくなっています。
また、これらとは別に、毛根が萎縮していたり、途中でちぎれていたりする「ジストロフィー毛(成長障害毛)」が見られることもあります。
これは、抗がん剤治療など、細胞分裂が急激に障害されることで生じるもので、成長期脱毛症の指標となります。
結果の解釈と診断への活用
トリコグラムの結果は、脱毛症の鑑別診断に非常に役立ちます。休止期毛の割合が高ければ休止期脱毛症、ジストロフィー毛が多ければ成長期脱毛症を強く疑います。
また、男性型および女性型脱毛症では、休止期毛の割合の増加とともに、毛幹(毛の本体部分)の太さが細くなっている所見が観察されます。
これらの情報を他の検査結果と照らし合わせることで、より診断の確実性を高め、個々の患者さんに合った治療計画を立てることが可能になります。
トリコスコピーとの違い
トリコスコピーが「頭皮を切らず、毛を抜かずに」観察する非侵襲的な検査であるのに対し、トリコグラムは「毛を引き抜いて」その毛根を直接観察する侵襲的な検査であるという点が大きな違いです。
トリコスコピーは頭皮全体の環境や毛髪の密度、太さのばらつきなどを広範囲に評価するのに適しています。
一方、トリコグラムはヘアサイクルの内部バランス、特に成長期と休止期の割合という、より詳細な情報を得ることに特化しています。両者は互いに補完しあう関係にあり、必要に応じて組み合わせて行います。

頭皮生検 – 病理組織学的診断
頭皮生検は、他の検査では診断が確定しない場合や、特殊な脱毛症が疑われる場合に行う、より詳細な検査です。
頭皮の組織を一部採取し、顕微経で調べる病理組織学的検査により、確定診断を下します。
頭皮生検が必要となるケース
頭皮生検は、全ての脱毛症患者さんに行うものではありません。主に、毛包が破壊されて永久的な脱毛を引き起こす「瘢痕性脱毛症」が疑われる場合に行います。
これには、毛孔性扁平苔癬(もうこうせいへんぺいたいせん)やジスクイドエリテマトーデス(DLE)などが含まれます。
また、円形脱毛症の中でも診断が難しいケースや、他の皮膚疾患との鑑別が必要な場合にも選択されます。臨床所見やトリコスコピーだけでは判断がつかない場合の最終的な診断手段と位置づけられています。
検査の流れと注意点

検査は局所麻酔下で行います。まず、診断に最も有用と考えられる部位を選び、消毒と麻酔をします。次に、パンチという円筒状のメスを用いて、直径数ミリ程度の皮膚組織を円形にくり抜きます。
通常は1〜2箇所から採取します。採取後は、傷口を縫合するか、自然にふさがるのを待ちます。採取した組織は、ホルマリンで固定し、染色などの処理を施した上で、病理医が顕微鏡で詳細に観察します。
検査後は、当日の激しい運動や飲酒を避ける、傷口を清潔に保つなどの注意が必要です。
生検で診断できる具体的な疾患
頭皮生検では、毛包周囲の炎症細胞の種類や分布、毛包自体の構造の変化、皮脂腺や立毛筋の状態などを詳細に観察できます。これにより、以下のような疾患の確定診断が可能です。
- 瘢痕性脱毛症全般 毛孔性扁平苔癬、ジスクイドエリテマトーデス、禿髪性毛包炎など、毛包が破壊される疾患の診断に重要です。
- 円形脱毛症 毛球部周囲に特徴的なリンパ球の浸潤(しんじゅん)を確認します。
- 皮膚T細胞リンパ腫 悪性リンパ腫が頭皮に現れた場合など、特殊な疾患の診断も可能です。
最終診断における生検の役割
頭皮生検は、脱毛症の原因診断における「最終兵器」とも言える役割を担います。特に、不可逆的な変化を伴う瘢痕性脱毛症を早期に診断し、治療を開始することは、脱毛範囲の拡大を防ぐ上で極めて重要です。
他の検査では類似した所見を示す異なる疾患も、組織レベルで観察することで明確に区別できます。
医師は病理診断の結果と臨床所見を照らし合わせ(臨床病理相関)、最終的な診断を確定し、最も適切な治療方針を決定します。

毛髪ミネラル検査 – 毛髪中の必須ミネラルや有害金属の測定
毛髪ミネラル検査は、体内のミネラルバランスを知るための検査です。髪の毛は血液や尿と比べて、長期的なミネラルの蓄積状態を反映するため、慢性的な栄養状態の評価に用いられます。
毛髪ミネラル検査の概要

この検査では、後頭部や側頭部の根本近くから少量(0.1g程度)の毛髪を採取し、専門の分析機関に送ります。
毛髪に含まれるナトリウム、カリウム、カルシウム、亜鉛といった必須ミネラルと、水銀、鉛、カドミウム、ヒ素などの有害金属の濃度を測定します。
血液検査がその時点での血中濃度を反映するのに対し、毛髪は過去数ヶ月間のミネラルの平均的な蓄積レベルを示すため、体の栄養状態や有害物質への暴露の履歴を推定するのに役立ちます。
測定できるミネラルの種類と役割
毛髪は体の排泄器官の一つであり、体内のミネラル成分が取り込まれます。この性質を利用して、健康状態を評価します。
必須ミネラルと毛髪の関係
毛髪の主成分はケラチンというタンパク質ですが、その合成には様々なミネラルが関与しています。
特に亜鉛は、細胞分裂やタンパク質の合成に深く関わり、不足すると毛髪の成長が妨げられ、脱毛の原因となることがあります。
また、鉄分が不足すると貧血になり、頭皮への酸素供給が滞って毛髪の健康に影響します。銅やセレンなども、毛髪の色素形成や抗酸化作用に関わる重要なミネラルです。
毛髪の健康に関わる主要ミネラル
| ミネラル名 | 主な働き | 不足による影響 |
|---|---|---|
| 亜鉛 | ケラチンの合成、細胞分裂の促進 | 脱毛、毛髪の菲薄化、成長遅延 |
| 鉄 | ヘモグロビンの構成成分、酸素運搬 | 頭皮の血行不良、抜け毛、ツヤの低下 |
| 銅 | メラニン色素の生成、結合組織の強化 | 白髪、毛髪の質の低下 |
| セレン | 抗酸化作用、甲状腺機能の維持 | 脱毛、毛髪の脆弱化 |
有害金属の蓄積リスク
一方で、水銀、鉛、ヒ素といった有害金属は、体内の酵素の働きを阻害するなどして、さまざまな健康被害をもたらします。
これらの金属が体内に蓄積すると、必須ミネラルの働きを妨げ、結果として毛髪の成長サイクルを乱したり、頭皮の炎症を引き起こしたりすることがあります。
毛髪ミネラル検査は、自覚症状が現れる前の段階で、これらの有害金属の蓄積レベルを把握するのに有効です。
検査結果の解釈と栄養指導
検査結果は、各ミネラルの基準値と比較され、過剰・不足のバランスが評価されます。結果に基づいて、医師や管理栄養士が具体的な食事指導やサプリメントの提案を行います。
例えば、亜鉛が不足していれば、牡蠣やレバー、赤身肉などの摂取を勧めます。
有害金属の蓄積が見られる場合は、デトックス(解毒)を促す食事指導や、汚染源の特定と回避に向けた生活習慣のアドバイスを行います。
ただし、結果の解釈は専門的な知識を要するため、必ず専門家のアドバイスを受けてください。
検査の限界と注意点
毛髪ミネラル検査は、あくまで体内のミネラルバランスを推定するための一つの指標であり、これだけで病気の診断が確定するわけではありません。
ヘアカラーやパーマなどの化学処理、整髪料の使用、居住地域の水質などが測定値に影響を与える可能性もあります。そのため、結果は血液検査や尿検査、問診など、他の情報と合わせて総合的に評価することが重要です。
また、この検査は多くの医療機関で自費診療となります。

頭皮脂質分析 – 皮脂の分泌状態の評価
頭皮の健康状態を左右する重要な要素の一つが皮脂です。皮脂は多すぎても少なすぎてもトラブルの原因となります。
頭皮脂質分析は、皮脂の量や質を科学的に分析し、頭皮環境を評価する検査です。
頭皮の皮脂が果たす役割
頭皮の皮脂腺から分泌される皮脂は、汗と混じり合って皮脂膜を形成します。
この皮脂膜は、頭皮の水分蒸発を防いで潤いを保つバリア機能と、外部の刺激や細菌の侵入から頭皮を守る保護機能という、二つの重要な役割を担っています。
また、皮脂に含まれる脂肪酸が頭皮を弱酸性に保つことで、雑菌の繁殖を抑える働きもあります。適度な皮脂は、健康な頭皮と毛髪を維持するために必要です。
皮脂分泌の過剰と不足がもたらす問題
皮脂の分泌バランスが崩れると、さまざまな頭皮トラブルにつながります。分泌が過剰になると、毛穴が詰まりやすくなり、ニキビや吹き出物の原因となります。
また、過剰な皮脂を栄養源としてマセラチア菌などの常在菌が異常増殖すると、フケやかゆみ、炎症を引き起こす脂漏性皮膚炎を発症することがあります。
逆に、皮脂の分泌が不足すると、頭皮のバリア機能が低下し、乾燥や外部刺激によるかゆみ、フケ(乾性フケ)が生じやすくなります。
分析方法と評価項目

頭皮脂質分析にはいくつかの方法があります。簡単な方法としては、吸脂性のシートを一定時間頭皮に押し当て、染み出した皮脂の量を視覚的に評価する方法があります。
より詳細な分析では、採取した皮脂をガスクロマトグラフィーなどの分析機器を用いて、脂肪酸の組成を調べます。
皮脂に含まれるトリグリセリド、ワックスエステル、スクアレン、遊離脂肪酸などの成分比率を分析することで、皮脂の「質」を評価します。特に、炎症を引き起こしやすい遊離脂肪酸の割合などを調べます。
脂漏性脱毛症との関連
脂漏性皮膚炎が頭皮で慢性的に続くと、炎症によって毛根がダメージを受け、毛髪の成長が妨げられることがあります。これにより抜け毛が増加する状態を「脂漏性脱毛症」と呼びます。
頭皮脂質分析によって皮脂の分泌過剰や質の異常が確認された場合、脂漏性皮膚炎やそれに伴う脱毛症のリスクを評価できます。
検査結果に基づき、皮脂分泌をコントロールする内服薬や外用薬、適切なシャンプー剤の選択など、具体的な治療・ケア方針を立てるのに役立ちます。

真菌培養検査 – 頭部白癬などの真菌感染症の診断
頭皮のかゆみやフケ、脱毛の原因が、カビの一種である真菌(しんきん)の感染による場合があります。真菌培養検査は、原因となる真菌の種類を特定し、確実な診断を下すために行います。
頭皮の真菌感染症とは
頭皮に起こる真菌感染症で最も代表的なものは「頭部白癬(とうぶはくせん)」です。一般的に「しらくも」とも呼ばれ、白癬菌という真菌が頭皮の角質層や毛髪に感染することで発症します。
円形に脱毛し、細かいフケやカサつきが見られるのが特徴です。ペットから感染することもあります。その他、カンジダやマラセチアといった真菌が原因で頭皮に炎症を起こすこともあります。
検査の対象となる症状
真菌培養検査は、以下のような症状が見られる場合に検討します。
- 境界が比較的はっきりした円形の脱毛斑がある
- 脱毛部分にフケやカサつき、かさぶたがある
- 毛が根本から折れたり、黒い点のように見えたりする
- 通常の湿疹や皮膚炎の治療薬(ステロイドなど)で改善しない、あるいは悪化する
これらの症状は、円形脱毛症や脂漏性皮膚炎など他の疾患と似ていることがあるため、鑑別のために検査が重要です。
検体の採取と培養の方法
まず、病変部のフケ、かさぶた、そして感染している可能性のある毛髪をピンセットやメスなどで採取します。この検体を、真菌の発育に適した培地(ばいち)が入った容器に植え付けます。
その後、培地を一定の温度・湿度に保たれた環境で数週間培養します。
もし検体中に真菌が存在すれば、培地の上でコロニー(集落)を形成して増殖してきます。
このコロニーの形状や色を観察したり、一部を採取して顕微鏡で胞子の形を調べたりすることで、真菌の種類を同定します。
診断確定と治療方針の決定
培養検査によって頭部白癬の原因菌などが特定されると、診断が確定します。頭部白癬の治療には、主に内服の抗真菌薬を用います。外用薬だけでは毛髪の内部に潜む菌まで十分に届かないためです。
培養検査で原因菌がはっきりすれば、その菌に効果の高い薬剤を選択できます。適切な治療を行うことで、菌を排除し、脱毛症状の改善と毛髪の再生を促します。
家族内やペットからの感染が疑われる場合は、同時に治療を行うことも大切です。

細菌培養検査 – 細菌性頭皮炎の原因菌同定
頭皮の毛穴に細菌が感染し、炎症を起こすことがあります。細菌培養検査は、その原因となっている細菌の種類を特定し、効果的な治療法を見つけるために行います。
細菌による頭皮トラブル
頭皮には多くの常在菌が存在し、通常は問題を起こしません。
しかし、頭皮のバリア機能の低下や不衛生な状態、傷などがあると、黄色ブドウ球菌やアクネ菌などが異常に増殖し、毛穴に感染して炎症を起こすことがあります。
これが「毛嚢炎(もうのうえん)」や「せつ(おでき)」です。症状としては、毛穴を中心とした赤み、腫れ、膿(うみ)を伴う痛みのあるブツブツなどが現れます。
重症化すると、脱毛の原因になることもあります。
検査が有効な頭皮の状態
細菌培養検査は、主に膿を持っているような化膿性の病変がある場合に有効です。
具体的には、頭皮の毛嚢炎が多発している、あるいは治りにくい場合や、かさぶたを伴うジクジクした湿疹(伝染性膿痂疹、とびひ)が頭皮に広がっている場合などに行います。
単なるかゆみやフケだけでは、通常この検査の対象とはなりません。原因菌を特定することで、なぜ症状が長引いているのかを解明する手がかりになります。
原因菌の特定と薬剤感受性試験
検査では、まず膿や浸出液を綿棒などで拭い、検体を採取します。この検体を、細菌の発育に適した培地に塗り、培養します。真菌と同様に、数日後には原因菌がコロニーを形成します。
そのコロニーの特徴を観察したり、生化学的なテストを行ったりして、細菌の種類を同定します(例 黄色ブドウ球菌など)。
さらに重要なのが「薬剤感受性試験」です。特定した細菌に対して、さまざまな種類の抗菌薬(抗生物質)を作用させ、どの薬が最も効果的かを調べます。
これにより、治療薬の選択ミスを防ぎ、耐性菌の出現リスクを減らすことができます。
適切な抗菌薬選択の重要性
薬剤感受性試験の結果は、治療方針を決定する上で極めて重要です。もし、原因菌に対して効果のない抗菌薬を使い続けても、症状は改善しないばかりか、かえって耐性菌を生み出してしまう危険性があります。
検査結果に基づいて、最も効果の高い抗菌薬の内服薬や外用薬を選択することで、迅速かつ確実に症状を抑え、炎症による毛根へのダメージを最小限に食い止めることができます。
特に、治療が長引いているケースでは、この検査が治療の突破口となることも少なくありません。
頭皮・毛髪の直接検査に関するよくある質問
- 検査は痛いですか?
-
ほとんどの検査は痛みを伴いません。トリコスコピーや毛髪引き抜き試験、各種培養検査の検体採取は、痛みを感じることはほぼありません。
トリコグラムは毛を数本抜くためチクッとした軽い痛みを感じることがあります。
頭皮生検は局所麻酔を使用するため、麻酔注射の際に少し痛みがありますが、検査中の痛みはありません。
- 検査にかかる時間はどれくらいですか?
-
検査自体にかかる時間は、トリコスコピーや毛髪引き抜き試験であれば数分程度です。トリコグラムや頭皮生検は、準備や処置を含めて15分から30分程度かかります。
ただし、培養検査やミネラル検査、病理検査は、結果が出るまでに数日から数週間を要します。
- 検査前に注意することはありますか?
-
正確な診断のため、検査当日は整髪料(ワックス、スプレー、オイルなど)の使用は控えてください。
また、前日の夜からシャンプーをしない方が、頭皮の皮脂の状態などをより正確に評価できる場合があります。詳しくは、受診する医療機関の指示に従ってください。
- 検査結果はすぐにわかりますか?
-
トリコスコピーや毛髪引き抜き試験は、その場で医師から説明を受けられます。
一方、トリコグラム、培養検査、頭皮生検、毛髪ミネラル検査など、外部の機関で分析や培養が必要な検査は、結果判明までに時間がかかります。
通常、1週間から4週間程度が目安です。
- 検査は保険適用されますか?
-
医師が脱毛症の診断や治療のために必要と判断した検査(トリコスコピー、各種培養検査、頭皮生検など)は、基本的に健康保険が適用されます。
ただし、毛髪ミネラル検査や頭皮脂質分析など、一部の特殊な検査は自費診療となることが一般的です。受診前に医療機関に確認することをお勧めします。
Reference
ORASAN, Meda Sandra; CONEAC, Andrei; ROMAN, Iulia Ioana. Evaluation of Patients with Alopecia. In: Alopecia. IntechOpen, 2018.
GUARRERA, M. Additional methods for diagnosing alopecia and appraising their severity. G Ital Dermatol Venereol, 2014, 149.1: 93-102.
ALESSANDRINI, A., et al. Common causes of hair loss–clinical manifestations, trichoscopy and therapy. Journal of the European Academy of Dermatology and Venereology, 2021, 35.3: 629-640.
LOSS, Evaluate Hair. New Diagnostic Tools to. Hair, An Issue of Dermatologic Clinics, E-Book: Hair, An Issue of Dermatologic Clinics, E-Book, 2021, 39.3: 375-381.
FALCON, Cristina Serrano; ESPINOZA, Nelly; GUZMAN, Daniela. Pull Test and Trichogram. In: Techniques in the Evaluation and Management of Hair Diseases. CRC Press, 2021. p. 30-43.
HILLMANN, Kathrin; BLUME-PEYTAVI, Ulrike. Diagnosis of hair disorders. In: Seminars in cutaneous medicine and surgery. No longer published by Elsevier, 2009. p. 33-38.
PILLAI, Jai Kumar. To Study the Role of Dermoscopy in the Diagnosis and Evaluation of Non-Cicatricial Hair Loss. 2018. PhD Thesis. Rajiv Gandhi University of Health Sciences (India).
TRÜEB, Ralph M.; DUTRA REZENDE, Hudson; GAVAZZONI DIAS, Maria Fernanda Reis. Diagnostic Techniques. In: Hair in Infectious Disease: Recognition, Treatment, and Prevention. Cham: Springer International Publishing, 2023. p. 367-404.
ANASTASSAKIS, Konstantinos. Hair growth assessment techniques in AGA/FPHL. In: Androgenetic Alopecia From A to Z: Vol. 1 Basic Science, Diagnosis, Etiology, and Related Disorders. Cham: Springer International Publishing, 2022. p. 97-115.
KATOULIS, Alexander C., et al. A Three-Step Diagnostic Algorithm for Alopecia: Pattern Analysis in Trichoscopy. Journal of Clinical Medicine, 2025, 14.4: 1195.

